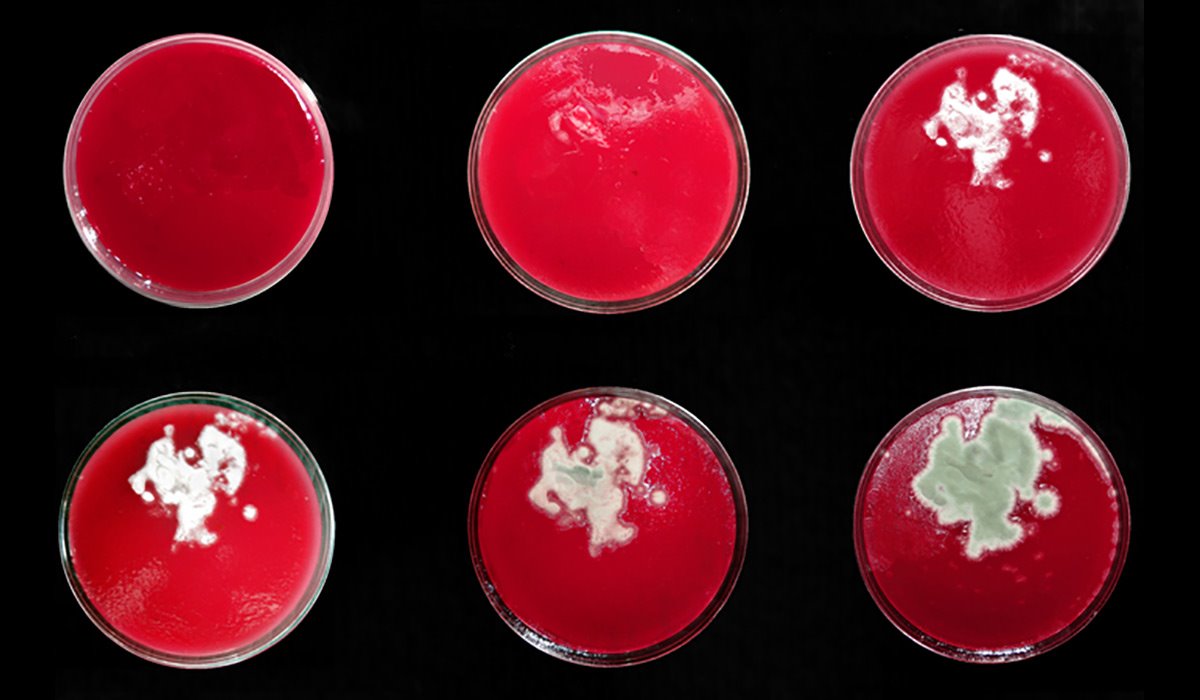

Collaborators
EcoLogicStudio
Exhibitions
Smart Geometry 2011
Copenhagen, Denmark
2011 ACADIA Conference
Banff, Canada
Publications
Inside Smart Geometry
Wiley, 2013
Proceedings of 2011 ACADIA Conference
CyberGarden v4 is a multilayered, intelligent system that passes electronic and biological information between layers of manufactured and biological materials. It utilizes a network of radiation sensors and custom robotic arms to create a self-regulated bacteria farming system. The system is shown as a scale model whereby bacteria could be cultivated at various rates to create different levels of shading within a transparent canopy structure through the density/opacity of the bacteria growth. The physical prototype and digital model engage in a generative dialogue and co-evolve over the course of each exhibition. The petri dish components are made of translucent perspex and when added to the physical model cause a change in the lighting field. This affects the digital plan and triggers the emergence of other gardening components to be designed, cut and added on.
Created for the 2011 Smart Geometry Conference Workshop Series.